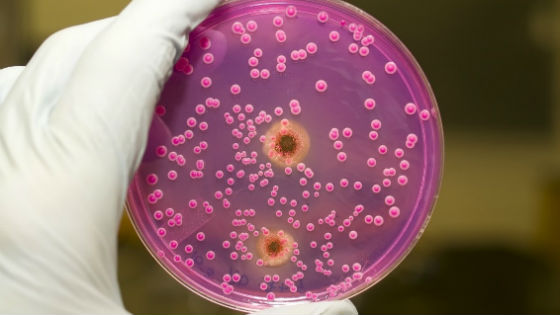

Молочница — распространенное заболевание в основном среди женской половины населения. Причины молочницы могут быть различны и непредсказуемы. Иногда даже ошибки в питании провоцируют недуг, а несвоевременное лечение приводит к частым рецидивам и даже преобразованию в хроническую форму. Симптоматика развития молочницы весьма неприятна и требует немедленного устранения.
Что такое молочница?
Болезнь получила свое название из-за характерной симптоматики — белых творожистых выделений, напоминающих молочные хлопья. Возбудитель молочницы — патогенный грибок рода Кандида. Этот микроскопический организм при нормальной микрофлоре слизистых оболочек находится там и не вызывает проблем. Но под воздействием негативных факторов грибок активно развивается. Вследствие этого и может начаться кандидоз (вагинальный, полости рта и др.).
Основные причины кандидоза у женщин, детей и мужчин
Одним из факторов, провоцирующим заражение вагинальным кандидозом являются инфекции, передающиеся половым путем от партнера к партнеру. У мужчин кандидоз возникает реже и зачастую течет бессимптомно. Женщины же наоборот, более подвержены инфицированию. Это связано с особенностями строения и расположения половых органов. Венерические инфекции, спровоцированные определенными возбудителями, сопровождаются характерными признаками, среди которых и молочница. Патологическая микрофлора создает благоприятные условия для размножения бактерий, кандидозных в том числе.
Причины возникновения молочницы для мужчин и женщин — некоторые недуги с хроническим течением. К ним относятся:
- эндокринные патологии, диабет;
- СПИД;
- болезни крови;
- кишечный дисбиоз;
- туберкулез;
- хронический тонзиллит;
- эрозия шейки матки (молочница появляется после биопсии).
Вернуться к оглавлению
Когда мужчина или женщина страдает онкологическим заболеванием (раком), выходит так, что они подвергаются лечению химическими препаратами. Именно воздействие химии провоцирует возникновение грибковой инфекции. Лечить молочницу сложно, порой избавиться от нее удается лишь на короткое время, часто после лечения молочница возвращается.
Появление молочницы связано с несоблюдением диеты и потреблением продуктов, которые считаются вредными. Например, частая молочница образуется от сладкого. Пищеварительные процессы в этом случае нарушаются, в кровь поступает избыточное количество сахара, а глюкоза помогает создать хорошие условия для развития грибка Кандида.
Основные причины частой молочницы у женщин — нарушения гормонального фона. К таким нарушениям относятся:
Когда организм испытывает интоксикационные симптомы, случается резкое снижение защитных иммунных сил организма. А это, в свою очередь, повод для развития кандидоза. Отравление сопровождается болезненными проявлениями молочницы, которые исчезнут вскоре после того, как организм восстановится после сильной интоксикации, а иммунитет повысится.
Причины появления молочницы у женщин, мужчин и детей считается прием антибиотиков с целью лечения заболеваний (простуды, цистита и др.). Это довольно эффективные средства, которые могут купировать воспалительный процесс и избавить человека от недуга уже через 3—4 дня. Побочной реакцией их употребления и считается активизация грибка рода Кандида. Происходит уничтожение полезных бактерий и нарушение микрофлоры слизистых оболочек.
Неправильное и легкомысленное отношение к уходу за половыми органами часто приводит к развитию патогенных микробов в интимной зоне. Неправильные собственноручные действия включают:
- Использование некачественных гигиенических прокладок и тампонов в период менструации. Пользование ежедневными прокладками на ароматизированной основе.
- Применение косметических средств для интимной гигиены, имеющие в составе ароматизаторы и добавки, за-за которых можно получить зуд и жжение половых органов.
- У девочек появляется молочница при неправильном мытье интимной зоны. Нужно подмываться от лобка к заднему проходу, а не наоборот. В противном случае получается так, что бактерии, локализующиеся около анального отверстия, попадают во влагалище.
- Часто появляется молочница у детей и взрослых при использовании цветной, и ароматизированной туалетной бумаги.
Вернуться к оглавлению
Изменение гормонального фона и резкое снижение иммунитета происходит в период вынашивания ребенка. Сниженный иммунитет — основная причина активизации жизнедеятельности кандидозных бактерий. Беременность и период кормления грудью — время, когда молочница может возникать часто, с небольшой периодичностью. После того как уровень эстрогена и прогестерона придут в норму, и увеличатся защитные силы организма, заболевание перестанет рецидивировать.
Существует еще много других причин, по которым происходит обострение и развитие кандидоза. Они представлены в таблице:
| Провоцирующие факторы | Описание |
| Стрессовые ситуации | Переживания и расстройства. От стрессов берется целая череда болезней, не исключением является и молочница. |
| Изменение климатических условий | Жаркий или влажный климат, сырая вода. Факторы могут спровоцировать размножение бактерий в интимной зоне. |
| Применение латексных презервативов | Аллергическая реакция на материал. Проявляется в виде зуда и отечности половых органов у одного из партнеров. |
| Переохлаждение | Ослабление защитных функций организма. |
Вернуться к оглавлению
Симптомы кандидоза
Распознать молочницу у женщины несложно. Характерные признаки недуга:
- обильные выделения белого цвета и творожистой консистенции;
- покраснение и отечность слизистой оболочки;
- зуд и жжение половых органов (внутри и снаружи);
- неприятные ощущения при мочеиспускании.
Симптоматика кандидоза у мужчин:
- образуется налет белого цвета на головке полового члена;
- раздражение и краснота пениса;
- боль при прикосновении;
- рези при мочеиспускании и занятии сексом.
- отек слизистой оболочки;
- белый налет и вкрапления на языке, небе, щеках;
- боль при глотании;
- неприятный запах изо рта.
Вернуться к оглавлению
Лечение заболевания
Терапия молочницы у новорожденных происходит без применения медикаментов. Стоит отрегулировать влажность в помещении, повысить иммунитет, и болячка пройдет сама по себе. Лечение же кандидоза у мужчин и женщин начинается с обращения к врачу (гинекологу, урологу или венерологу). Далее, доктор назначает диагностическое обследование и анализы, на основании результатов которых можно узнать точный диагноз. Если выявлена молочница и определены способы заражения, терапия проводится препаратами противогрибкового действия. Лекарственные средства для лечения кандидоза выпускаются в форме таблеток, мазей, суппозиториев. Самые распространенные:
Когда бывает молочница у мужчин и женщин, из рациона исключают сладости, жирную и жареную пищу. Нужно каждый день делать зарядку, совершать пешие прогулки. Умеренные физические нагрузки положительно повлияют на исходный результат лечения. А также следует регулярно дезинфицировать сиденье унитаза, менять нижнее белье. Очень важно избегать переохлаждения. Во время лечения молочницы запрещено заниматься сексом, осторожность связана с тем, что может заразиться один из партнеров.
Многие женщины знают, какие неприятные симптомы бывают при молочнице. Дискомфорт, зуд и жжение во влагалище лишают покоя, доводят до нервного срыва. На какое-то время болезнь утихает, но в любой момент происходит обострение. Многие недоумевают, откуда берется грибок и как можно им заразиться, каковы причины появления молочницы у женщин. Все, что способствует гибели полезных лактобактерий, провоцирует образование болезнетворной микрофлоры. Укрепление иммунитета является важной мерой профилактики размножения инфекции в организме.
Содержание:
- Как возникает молочница
- Симптомы молочницы
- Причины возникновения молочницы
- Ослабленный иммунитет
- Гормональный фон
- Изменение состава микрофлоры влагалища
- Нарушение норм гигиены
- Чем опасна молочница
- Профилактика молочницы
Как возникает молочница
Молочницей называют кандидозный вагинит – инфекционное грибковое заболевание. Грибки рода кандида, его возбудители, относятся к представителям условно-патогенной микрофлоры. Это означает, что они в небольшом количестве являются нормальными обитателями кожи и всех слизистых организма, не принося вреда до определенного момента.
Болезнь возникает, когда грибок начинает безудержно размножаться. Нормальная микрофлора влагалища содержит около 40 видов живых микроорганизмов, причем в ней должны преобладать молочнокислые бактерии (палочки Дедерлейна) и бифидобактерии. Они препятствуют развитию болезнетворных микробов. Грибы начинают бесконтрольно размножаться, если у человека по какой-то причине снижается иммунитет (после операции или стресса, например).
Развитию грибов благоприятствует теплая (21°-37°), влажная слабокислая среда. Убить грибки можно только с помощью специальных антигрибковых препаратов, разрушающих их структуру.
Интересно то, что от молочницы невозможно избавиться с помощью пробиотиков – препаратов, повышающих содержание молочнокислых бактерий. Избыток лактобактерий, наоборот, усиливает рост грибка, так как кислая среда убивает лишь его конкурентов, которым для жизни нужна слабощелочная среда. Грибы же в кислой среде прекрасно развиваются.
Заражение грибком происходит как бытовым путем (через постельное белье, банные полотенца), так и половым.
Симптомы молочницы
Проявления молочницы трудно не заметить. У женщины возникают характерные обильные выделения, напоминающие творожистую массу. Они белого цвета, имеют запах кислого молока. Благодаря этим признакам заболевание и получило свое неофициальное название.
На слизистых оболочках влагалища наблюдается белый налет. Во влагалище ощущается сильный зуд. Он усиливается после менструации, во время полового акта. Состояние усугубляется к вечеру. Рези и жжение особенно чувствуются в жару или после бани.
Причины возникновения молочницы
Главными причинами возникновения молочницы у женщин, дающими толчок к развитию грибов во влагалище, являются:
- снижение иммунной защиты;
- изменение гормонального фона в организме;
- нарушение состава бактериальной среды и кислотности влагалища;
- несоблюдение правил гигиены;
- употребление в пищу большого количества сладких и мучных продуктов.
Возникновению этих причин способствует множество факторов.
Состояние иммунной системы у женщины зависит от ее здоровья, физической формы, условий и образа жизни, характера питания, наличия вредных привычек. Резкому снижению иммунитета способствует возникновение хронических заболеваний различных органов (печени, почек, сердца, кишечника). Нагрузка на иммунную систему повышается при наличии воспалительных процессов, травм, после хирургических операций.
Человек чаще болеет, если организм ослаблен из-за неправильного питания (голодания, недостатка белков и витаминов в пище), недосыпания, истощения нервной системы, отсутствия нормальных санитарно-бытовых условий. Малоподвижный образ жизни, отсутствие закалки приводят к тому, что человек часто болеет простудными заболеваниями, отнимающими силы, необходимые для защиты от инфекции. Курение, пристрастие к алкоголю, наркотическая зависимость также увеличивают чувствительность к инфекциям, могут стать причиной обострения молочницы.
Соотношение различных гормонов взаимосвязано с работой репродуктивной системы. Нередко молочница обостряется перед менструацией, во время беременности, при климаксе. Это связано с влиянием гормонов на состояние половых органов, структуру их слизистых оболочек, восприимчивость организма к инфекции.
Причиной гормональных изменений может быть употребление гормональных лечебных препаратов и контрацептивов, эндокринные заболевания, нарушение обмена веществ. Нередко причинами молочницы у женщин становится сахарный диабет, ожирение, нарушение работы щитовидной железы.
Причинами нарушения бактериальной флоры могут быть:
- Длительное или бесконтрольное употребление антибиотиков. Убивая болезнетворные бактерии (стрептококки, стафилококки), они попутно уничтожают полезную микрофлору, сдерживающую рост грибов, что приводит к их избыточному росту в кишечнике, откуда грибок может легко попасть во влагалище.
- Частое спринцевание, использование щелочных средств для интимной гигиены. Происходит вымывание полезных бактерий, изменение кислотности среды, пересушивание слизистой оболочки влагалища.
- Неправильное применение пробиотиков для лечения бактериального вагиноза. Их можно использовать в целях восстановления бактериальной среды только при отсутствии грибков в микрофлоре.
- Употребление в пищу большого количества сладостей, изделий из дрожжевого теста. Кроме того что создается благоприятная среда для развития грибков, происходит еще и повышение содержания сахара в крови, способствующее возникновению сахарного диабета.
Дополнение: Изменение микрофлоры влагалища происходит также при смене полового партнера. Молочницу не относят к венерическим заболеваниям, однако заражение женщины во время полового акта происходит нередко. У мужчин заболевание обычно протекает в скрытой форме, поэтому заражение вполне возможно при незащищенном половом контакте.
Причиной обострения молочницы может стать неправильный уход за половыми органами, в том числе во время менструации, редкая смена нижнего белья и гигиенических прокладок. Размножению грибка способствует ношение тесных синтетических трусиков, благоприятствующих проникновению инфекции во влагалище из кишечника.
Чем опасна молочница
Это заболевание представляет опасность, в первую очередь, при беременности, так как во время родов может произойти инфицирование плода. Врожденная молочница у ребенка провоцирует появление различных воспалительных заболеваний. Грибки кандида начинают развиваться в слизистой рта, кишечника, легких малыша.
Женщина заражает молочницей мужчину, даже не подозревая этого, если болезнь переходит в хроническую форму и ее признаки на какое-то время исчезают. Неприятные симптомы осложняют половую жизнь.
Молочница часто становится первым признаком сахарного диабета, наличия ВИЧ. Она осложняет лечение других сопутствующих инфекционных болезней половых органов.
Профилактика молочницы
Для того чтобы снизить риск развития кандидоза, женщина должна заботиться об укреплении иммунитета (этому способствует закаливание, активный отдых на свежем воздухе, борьба с нехваткой витаминов в организме). Необходимо контролировать массу тела и обмен веществ. Для этого надо ограничить употребление сладких и печеных изделий, соли, жирной пищи.
Важной мерой профилактики является своевременное лечение эндокринных расстройств, воспалительных и других заболеваний половых органов.

Предупреждение: Антибиотики и гормональные средства необходимо применять только в дозах, предписанных врачом.
Требуется поддерживать нормальную работу кишечника (избегать запоров, диареи). Рекомендуется носить белье из натуральных материалов, минимизировать использование ежедневных прокладок. При молочнице нельзя курить, употреблять спиртные напитки.
Молочница, или вульвовагинальный кандидоз — это грибковое заболевание женских наружных половых органов, вызываемое организмами Candida.
В организме большинства людей они постоянно присутствуют в организме и не приносят вреда. Но существует огромное количество патогенных факторов, приводящих к усиленному росту количества грибков.
О возбудителе заболевания
Возбудителем данной патологии являются условно патогенные организмы Candida. Они очень распространены: хотя бы раз в жизни молочницей болели примерно 80% женщин.
Кандиды способны проникать в организм во время половых контактов без использования контрацептивов или в результате плохого соблюдения правил гигиены. У женщин кандиды активизируются в результате приема пероральных противозачаточных препаратов.
Кандиды способны поражать многие органы. Чаще всего они вызывают воспаление гениталий. Нередко кандидоз развивается в области полости рта. Кандиды способны поражать:
- органы пищеварительного тракта;
- кожу, в частности, область подмышечных, межъягодичных складок;
- легкие.
Без адекватного лечения кандиды очень устойчивы к лечению. В таком случае у человека развивается хроническая молочница.
Грибки способны вызывать генерализованное заражение. Оно является причиной развития бесплодия, заражения плода, выкидыша.
Как проявляется молочница
Общие симптомы вульвовагинальной молочницы такие:
- появление неоднородных выделений из влагалища с неприятным запахом;
- раздражение слизистой гениталий;
- сыпь на поверхности половых органов;
- зуд и жжение, которые не исчезают даже после гигиенических процедур;
- отек вульвы, боль при прикасании к ней;
- учащение мочеиспускания;
- появление ссадин на наружных гениталиях;
- боль во время коитуса.
Генерализованная форма патологии проявляется лихорадкой, слабостью в мышцах, появлением абсцессов в почках и печени.
Причины появления грибкового поражения половых органов
Существует большое количество причин появления молочницы у женщин. Они связаны со стрессами, постоянной усталостью, неправильным питанием, нарушением баланса гормонов, гигиены, неправильным лечением, наличием определенных заболеваний.
Неправильное питание провоцирует развитие у женщин молочницы. Способствуют возникновению этого заболевания такие продукты:
- сахар;
- изделия из муки высшего сорта;
- продукты, сделанные из дрожжевого теста;
- фрукты;
- спиртные напитки, особенно вино и пиво;
- кофе.
При молочнице все эти продукты нужно исключить или свести их содержание к минимуму.
У женщин соотношение гормонов изменяется очень часто. Наиболее резкие изменения баланса гормонов наблюдаются перед овуляцией, во время климакса или из-за заболевания эндокринной системы.
Любое нарушение гормонального уровня изменяет функционирование слизистых влагалища, что приводит к патологической активности грибков.
К факторам, способствующим развитию вагинальной молочницы, относят ношение тесного белья, особенно стрингов, неправильное подмывание. Грибковое заболевание вагины развивается в случае, если женщина пользуется туалетным мылом.
Молочница может появляться и в случае, если женщина недостаточно внимания уделяет интимной гигиене. Из-за скопления болезнетворных микробов значительно нарушается баланс микрофлоры влагалища, отчего в нем начинают доминировать дрожжевые грибки.
Поражение организма диабетом приводит к нарушению снабжения кровью органов. Это приводит к развитию кислородного голодания клеток и тканей. Так как к ним не поступает достаточно кислорода, у них снижается местная иммунная защита.
Благоприятной средой для развития дрожжевых грибков является сахар, в избыточном количестве находящийся в крови. Замедленное заживление ран способствует более глубокому проникновению инфекции.
Стрессы и постоянная усталость способствует повышенной активности грибковой инфекции из-за снижения защитных сил организма. При стрессе нарушается работа всего организма, что провоцирует характерные изменения микрофлоры женских половых органов.
Особенности питания
Соблюдая правильное питание в комплексе с медикаментозным лечением, можно уменьшить продолжительность заболевания и снизить риск возникновения осложнений. Кроме того, диета поможет нормализовать деятельность кишечника, замелить размножение патогенных микроорганизмов – грибков.
Кроме того, что требуется соблюдение правильного питания с включением в рацион и ограничением определенных продуктов, рекомендуется придерживаться принципа употребления разрешенной пищи (совместно или раздельно). Углеводы употребляют с сырыми и свежими овощами, так же, как и мясо, так как они с мясными продуктами практически несовместимы.
Употребление простых углеводов (кондитерской продукции, белого хлеба, картофеля) способствует снабжению кишечника сахаром, который и вызывает рост патогенных микроорганизмов. Менее быстрое усвоение у сложных углеводов (круп, фруктов, орехов, бобовых, ягод), которым стоит отдать предпочтение.
Важно нормализовать питьевой режим, употребляя в день до 2 л воды. Во время приема пищи воду и любую другую жидкость (сок, компот, морс и др.) исключают. Рекомендуется пить за 15-20 минут до еды и через час после нее.
Соблюдают правильное питание на весь период лечения заболевания и на протяжении последующих нескольких недель после устранения молочницы.
Опасные продукты
Патогенные микроорганизмы – грибки рода кандида чувствительны к любым изменениям в питании человека. Поэтому стоит исключить из рациона те продукты, которые создают благоприятную среду для их размножения.
В первую очередь специалисты рекомендуют ограничить употребление сладостей. Полностью исключить риск развития молочницы можно, исключив из рациона сахар. В небольшом количестве разрешается употреблять мед, добавляя в чай. Кроме того, это поможет привести в норму вес, нормализовать состояние кожных покровов.
Второй вредный продукт – шлифованный рис, который быстро переваривается и способствует повышению уровня глюкозы в крови. Полезнее будет бурый рис.
Белые сорта хлеба вызывают повышение объема сахара в крови. По мнению диетологов – это полезный продукт, однако лишь тогда, когда приготовлен из цельного зерна. В его составе – легкоусвояемые углеводы, витаминные вещества, ферменты.
Идеальная среда для активизации грибковой инфекции создается дрожжами и пищей, которая из них приготовлена. По этой причине из рациона исключают дрожжевую выпечку. Конечно, можно кушать такие продукты, но только не в период лечения молочницы, вызванной грибками типа кандида.
Газированная вода и сладкие напитки с включением газа содержат большой объем сахара. Например, маленькая бутылка кока-колы содержит 45 г сахара, а емкость 2 л – около 200 г.
Жирные продукты так же исключают из рациона. Вместо свинины лучше на стол подавать курицу, а вместо обычного молока – обезжиренное. Сметану – вовсе исключить на время лечения кандидозной инфекции.
Свежие фрукты, бесспорно, имеют огромную пользу для организма, но не во время развития молочницы. Это касается и сладких ягод, но не всех. Некоторые из них обладают противогрибковым действием.
Запрещено употребление и следующих продуктов:
- грибов в любом виде;
- арахиса, масла на его основе, фисташек;
- сыров, особенно, плавленых, голубого и заплесневелого вида;
- соленостей и копченостей;
- переработанной и рафинированной пищи, которая богата дрожжами, сахаром, химикатами, консервантами, пищевыми красителями.
Кроме запрещенных продуктов существует и много полезных, которые благоприятно воздействуют на развитие заболевания, ускоряя выздоровление.
Полезные продукты
Хорошо борется с патогенными микроорганизмами, способствующими активизации грибков, яблочный уксус. В его составе – много естественных ферментов, которые замедляют рост патогенов, создают неблагоприятные для них условия. Однако важно выбрать натуральное средство, без консервантов, искусственных компонентов.
Полезно употребление квашенной капусты, которую можно кушать в чистом виде, добавлять в салаты. В ней содержатся пробиотические вещества, нормализующие переваривание пищи в ЖКТ и, укрепляющие защитную функцию организма. Капуста способствует заселению кишечника полезными бактериями, которые быстро устраняют патогенов – грибков.
Стоит включить в рацион томаты, огурцы, лук. Таковые употребляют в чистом виде, приготавливают на их основе первые и вторые блюда. В зеленых листовых овощах содержится фолиевая кислота, полезная для состояния ЖКТ в период терапии кандидоза.
Внутрь можно употреблять кокосовое масло по 1 ч. л. в день или же добавлять в процессе приготовления блюд. В его составе – противогрибковые компоненты – киприловая и лауриновая кислоты. Таковые ограничивают рост грибков и способствуют их уничтожению. Кроме того, кокосовое масло очищает организм от токсических веществ.
В десятке полезных продуктов при кандидозе – чеснок, который по своему действию имеет сходства с антибактериальными препаратами. Содержит аллицин – вещество, обладающее противогрибковым эффектом.
К полезным на период лечения молочницы продуктам относят и следующие:
- овощи, в составе которых отсутствует крахмал;
- несладкие ягоды и фрукты;
- свеклу;
- брюссельскую капусту;
- брокколи;
- огурцы;
- морковь;
- зелень;
- сливы;
- зеленые яблоки;
- мясо постного сорта в отварном виде;
- куриные яйца;
- морепродукцию;
- крупы безглютеновые;
- бобовые.
Полезна и кисломолочная продукция, которая богата бифидо- и лактобактериями: кефир, нежирная сметана, творог, йогурт без добавления сахара. Такие продукты способствуют торможению процесса активизации патогенов.
Примерное меню
Для составления меню можно обратиться к лечащему врачу или диетологу, который подробно объяснит, какие продукты можно совмещать, а какие лучше употреблять по отдельности.
Примерное меню на 3 дня можно поместить в таблицу:
| День недели | Время приема пищи | Продукты |
| Понедельник | Завтрак | Овсянка, сваренная на воде, сливочное масло, чай, яблоко |
| Второй завтрак | Ряженка – 200 мл | |
| Обед | Щи, куриная грудка в отварном виде, гречка, сваренная на воде, свежие овощи (салат), сок граната | |
| Полдник | 1 апельсин | |
| Ужин | Котлеты из рыбы, пюре из картофеля, чай из ромашки, зверобоя, календулы (на выбор) | |
| Вторник | Завтрак | Пшено, сваренное на молоке, чай или травяной настой |
| Второй завтрак | Яблочный сок, хлебцы | |
| Обед | Суп с горохом, говядина в отварном виде, овощи в тушеном виде, салат из несладких фруктов, зеленый чай | |
| Полдник | Натуральный йогурт без добавления сахара | |
| Ужин | Куринные яйца в виде парового омлета, настой ромашки | |
| Среда | Завтрак | Сырники, зеленый чай, лимон |
| Второй завтрак | Сок из моркови, хлебцы или крекеры | |
| Обед | Овощной суп с цветной капустой, рыба (филе), приготовленная на пару, бурый рис, чай | |
| Полдник | Зеленое яблоко | |
| Ужин | Свежие овощи в виде салата, куриные котлеты, приготовленные на пару, шиповниковый чай |
Питание при иных видах молочницы
Кандидоз полости рта требует исключения из рациона сладостей, кондитерской продукции, пищи с дрожжами в составе. Запрещается употребление грибов, жирного мяса, острых специй, пряного, кислого. Под запретом – спиртное, крепкий кофе, свежие овощи и фрукты. Из полезных продуктов – кисломолочная продукция, нежирная рыба и мясо, крупы.
Молочница пищевода – редкое и трудно диагностируемое заболевание. В таком случае исключают из рациона сладкое, включая варенье и мед, сахар, спиртное, выпечку, цельное молоко. Полезными будут ряженка, творог, йогурт, пища с клетчаткой в составе.
Кандидоз кожного покрова требует соблюдения правильного питания, которого придерживаются и при иных разновидностях заболевания. Важное условие – исключение алкогольной продукции, быстрых углеводов, нормализация уровня сахара в организме.
Соблюдая правильный рацион, можно ускорить выздоровление и уменьшить выраженность клинических проявлений. Однако, полностью устранить заболевание можно только комплексной терапией, то есть диетой, которой придерживаются в комплексе с медикаментозным лечением.
Читайте также:








